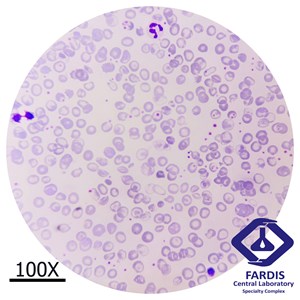

مشخصات مورد
- جنس: خانم
- سن: 22سال
یافته های هماتولوژی مورد
|
WBC |
77690 |
Neutro% |
36.1 |
|
RBC |
4.24 |
Lymph% |
50.5 |
|
Hgb |
10.8 |
Mono% |
10.5 |
|
Hct |
32.9 |
Eos% |
2.5 |
|
MCV |
77.6 |
Baso |
0.4 |
|
MCH |
25.5 |
Hb F |
98.2 |
|
MCHC |
32.8 |
Hb A2 |
1.8 |
|
PLT |
743000 |
Polychromatophilic Normoblast |
4 |
|
RDW-CV |
23.7 |
Orthochromatic Normoblast |
418 |
|
PDW |
11 |
Howell-Jolly |
++ |
|
MPV |
9.8 |
Aniso. |
+++ |
|
P-LCR |
42.2 |
Hypo.
|
+ |
|
PCT |
0.73 |
Polychroma |
++ |
|
|
|
Poikilocyt |
+ |
ثبت در بخش هماتولوژی آزمایشگاه مرکزی فردیس
اطلاعات علمی
تالاسمی بتا هموزیگوت(تالاسمی ماژور) در نتیجه فقدان زنجیره β یا کاهش چشمگیر آن رخ می دهد. تجمع زنجیره های آلفا ناپایدار است و در نرموبلاست ها و اریتروسیت ها رسوب می کند و منجر به تخریب سلولی و تولید هِم، هِمین، آهن که به عنوان مرکز تولید گونه های فعال O2 عمل میکنند، می شود. این فرآیند باعث اریتروپوئز غیرموثر و آنمی همولیتیک شدید می شود.
یافته های بالینی
زردی، اسپلنومگالی که در اوایل کودکی مشخص می شوند. استخوان پیشانی و گونه بزرگ و ظاهری مشابه مغولی ها.
گستره خون محیطی
- آنمی میکروسیت هیپوکروم
- پویکیلوسیتوز
- تارگت سل
- اوالوسیت
- حلقه های کابوت
- اجسام هاول-ژولی
- سیدروسیت
- آنیزوکروم و آنیزوسیتوز
- افزایش نورموبلاست ها در گستره خون محیطی
پویکیلوسیتوز به ویژه در افراد دارای طحال سالم دیده می شود در حالیکه RBC های هسته دار، پس از اسپلنکتومی افزایش می یابد. این افراد نیاز به دریافت خون مداوم دارند که باعث تجمع آهن در بدن آنها می شود که علت اصلی مرگ در آنها نارسایی قلبی به علت سیدروز قلبی است.
تهیه شده در کمیته علمی پژوهشی مجتمع آزمایشگاهی مرکزی فردیس
منبع: کتاب تشخیص و پیگیری بیماری ها به کمک روشهای آزمایشگاهی هنری دیویدسون